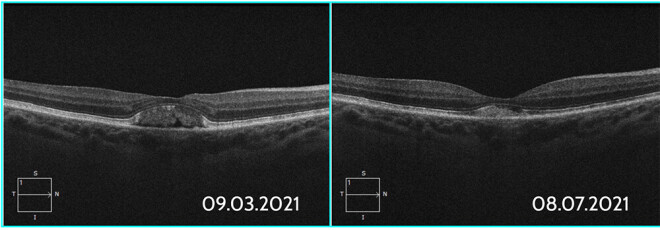
Divi tīklenes attēli šķērsgriezumā, kas ir uzņemti ar 4 mēnešu starpību – pirms un pēc tīklenes rejuvenācijas terapijas pacientam ar Vitelliform dystrophia, kas ir ģenētiski pārmantota. Pacients var nejust izmaiņas redzē, bet attēls skaidri parāda, kā šūnu līmenī notiek reālas, pozitīvas izmaiņas.

Reģenerēt acs šūnas, lai nezaudētu redzi?
Nav noslēpums, ka, augot gadu skaitam, organismā attīstās dažādi novecošanas procesi. Viena no tā sauktajām vecuma slimībām ir VECUMA IZRAISĪTA MĀKULAS DEĢENERĀCIJA (VMD). Grūti pamanāmas, bet dramatiskas izmaiņas acs tīklenē, jo, ja šī slimība ir radījusi redzes zudumu, redzi nav iespējams atjaunot.
Sekojot rietumvalstu praksei, Dr. Lūkina acu klīnika piedāvā novatorisku pieeju cīņā ar vecuma izraisītu mākulas deģenerāciju – īpašu lāzerterapiju, kas rejuvenē jeb reģenerē bojātās acs šūnas, lai apstādinātu mākulas deģenerācijas attīstību vēl pirms redze ir zaudēta kādā no acīm.
Kas ir šī slimība un vai šūnu rejuvenācija var glābt no redzes zuduma, konsultē Dr. Lūkina acu klīnikas dibinātājs un acu ķirurgs Dr. Fēlikss Lūkins un lāzeroftalmoloģe Dr. Žanna Artiņa.

Rietumu pasaulē visizplatītākais redzes zuduma iemesls
Mākula ir vieta tīklenē ar visasāko redzi. Tas ir reģions, kurā fotoreceptori (šūnas, ar kurām mēs redzam) atrodas īpaši blīvi. Vecuma izraisīta mākulas deģenerācija skar centrālo tīkleni un izraisa centrālā redzes asuma zudumu. Process ir ļoti lēns, tas attīstās gadiem.
Acs struktūrām novecojot, tās zaudē savas aktīvās funkcijas un starp acs slāņiem sāk uzkrāties dažādi vielmaiņas sabrukuma produkti, ko dēvē par drūzām – VMD attīstības pazīme. Vācijā 50 % gadījumu VMD ir galvenais iemesls smagiem redzes traucējumiem un redzes zudumam.
Vēlākajās saslimšanas stadijās tīklene ar fotoreceptoriem ir neatgriezeniski deģenerējusies. Skartajā acī var attīstīties VMD mitrā forma, un tikai daļā gadījumu ar regulārām medikamentu injekcijām acī izdodas pasargāt pacientu no redzes zaudēšanas.

Piezogas gandrīz nemanot
Ļoti agrīnā stadijā cilvēks nejūt izmaiņas redzē, bet tās var novērot, veicot tīklenes fotogrāfiju vai optisko koherento tomogrāfiju (OCT). Pirmās izmaiņas redzē ir minimālas: viegla miglošanās vaI līniju liekšanās centrālajā redzes laukā, bet, slimībai attīstoties, redzes kropļojumi kļūst izteiktāki – centrālajā laukā zūd krāsas, parādās pelēks vai melns nekustīgs plankums, kas nepazūd –, līdz pēdējā stadijā cilvēks uztver vairs tikai apkārt esošo, perifēro redzes lauku – nav iespējams lasīt, vadīt automašīnu vai pat skatīties televīziju.
Slimība, kas kļūst jaunāka
Daudzi pētījumi liecina, ka vecuma izraisīta mākulas deģenerācija, tāpat kā daudzas citas slimības mūsdienās, kļūst arvien “jaunāka”. VMD attīstību vecumā tiešā veidā ietekmē dzīvesveids – stress, mazkustība, neveselīgs uzturs, paaugstināts asinsspiediens, smēķēšana un ģenētika. Ja ģimenē vecākā paaudze ir slimojusi ar VMD, pastāv liela varbūtība, ka tā attīstīsies arī nākamajās paaudzēs.
Statistika rāda, ka agrīnās VMD simptomi ir katram desmitajam 50–65 gadu vecumā, katram piektajam 65–74 gadu vecumā un katram trešajam 75–84 gadu vecumā.
Nobela prēmija fizikā
Beidzamo gadu jaunums VMD ārstēšanā ir tīklenes rejuvenācijas terapija, kas Latvijā kopš 2018. gada tiek veikta Dr. Lūkina acu klīnikā Rīgā. Klīnika ir vienīgā Baltijā, kur ir pieejama jaunā lāzerterapija, kas ir īpaša ar to, ka tiek lietota slimības agrīnajā stadijā. Metode izgudrota 2012. gadā, bet 2018. gadā ultraīsas ekspozīcijas lāzerstaram oftalmoloģijā piešķirta Nobela prēmija fizikā. Lāzeru ir radījis austrāliešu uzņēmums Ellex sadarbībā ar vienu no pasaules slavenākajām acu klīnikām – Morfīldas slimnīcu Londonā. Šis ir pirmais lāzers, kura efektivitāte agrīnā VMD ārstēšanā ir oficiāli atzīta Eiropas Savienībā.

Rejuvenēt jeb reģenerēt acs tīkleni
Tīklenes rejuvenācijas terapija ir unikāla lāzera terapija, kas, izmantojot maigu, ārkārtīgi īsu impulsu lāzeru, absorbējas audos bez termāla bojājuma un stimulē dabisku tīklenes atjaunošanās procesu, apstādinot VMD attīstību vidēji uz pieciem gadiem. Tā ir neinvazīva un nesāpīga ārstēšanas metode. Terapija tiek veikta ambulatori klīnikā. Tās ilgums ir dažas minūtes, un pēc tās var turpināt ikdienas rutīnu. Terapijas laikā acs tīklenē tiek stimulēta dabīga bioloģiskā reakcija, kuras laikā sākas šūnu reģenerācijas process. Reģenerācija notiek lēni. Rezultāti ir redzami ne ātrāk kā 3–6 mēnešus pēc terapijas vai pat vēlāk, atkarībā no katra organisma.
Profilaktiska pārbaude var pasargāt no redzes zuduma
Tīklenes rejuvenācijas terapija tiek lietota slimības agrīnajā stadijā vēl pirms šūnas ir neatgriezeniski bojātas. Agrīnajā stadijā cilvēks nejūt redzes izmaiņas, tādēļ arī tad, ja sūdzību par redzi nav, sasniedzot 50 gadu slieksni, reizi gadā ir jāpārbauda acs tīklene, jo tas ir vienīgais veids, kā agrīni pamanīt VMD.
Saprot tie, kuri ar to jau ir saskārušies
Tīklenes rejuvenācijas terapija nevar atjaunot zaudēto redzi, bet var palīdzēt līdz tam nenonākt. Diemžēl daudzi klīnikā ierodas tikai tad, kad redze jau ir zaudēta kādā no acīm, lai glābtu otru aci. Citi nogurst no regulārām medikamentu injekcijām acīs un meklē mūsdienīgāku risinājumu. Ne visiem var palīdzēt, bet, jo ātrāk pacientam diagnosticē VMD, jo labākas ir iespējas.

Tehnoloģijas, kas uzlabo cilvēku dzīvi
Dr. Lūkina acu klīnika 2003. gadā sāka savu darbību kā redzes lāzerkorekcijas klīnika, bet šodien klīnikā ir pieejami mūsdienīgi pakalpojumi visai ģimenei. Klīnikā var veikt redzes lāzerkorekciju Latvijā vienā no plašākajiem dioptriju spektriem; tīklenes rejuvenācijas terapiju, lai nepieļautu VMD radītu redzes zudumu; stiklveida ķermeņa dzidrināšanas terapiju, lai atbrīvotos no peldošajiem plankumiem (tā sauktajām mušiņām, tārpiņiem) acu priekšā. Vairākus gadus pastiprināta uzmanība tiek pievērsta bērnu veselībai – klīnikā ir pieejamas nakts lēcas bērniem – mūsdienīga metode, kas var palēnināt vai
apturēt tuvredzības progresu bērniem, vienlaicīgi atbrīvojot no briļļu lietošanas ikdienā. Vairāk iespējams uzzināt klīnikas mājaslapā – www.acuklinika.lv.
Reklāmas raksts tapis sadarbībā ar Dr. Lūkina acu klīnika